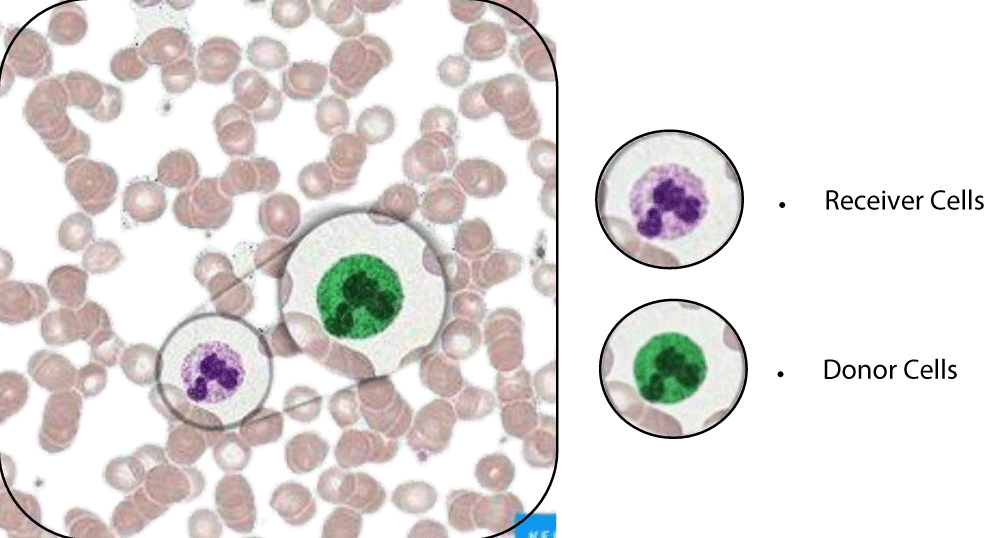

Figure 1
Forensic Perspectives on Human Chimerism: Identification Challenges and Detection Strategies
Harsh Kumar and Saumya Tripathi*
Published: 09 September, 2025 | Volume 9 - Issue 2 | Pages: 150-154
Figure 1:
Read Full Article HTML DOI: 10.29328/journal.jfsr.1001095 Cite this Article Read Full Article PDF
More Images
Similar Articles
-
Forensic Perspectives on Human Chimerism: Identification Challenges and Detection StrategiesHarsh Kumar,Saumya Tripathi*. Forensic Perspectives on Human Chimerism: Identification Challenges and Detection Strategies. . 2025 doi: 10.29328/journal.jfsr.1001095; 9: 150-154
Recently Viewed
-
Psychosis in Parkinson’s Disease and Current Management Trends- an Updated Review of LiteratureRajib Dutta*. Psychosis in Parkinson’s Disease and Current Management Trends- an Updated Review of Literature. J Neurosci Neurol Disord. 2023: doi: 10.29328/journal.jnnd.1001078; 7: 027057
-
Synergistic Approach: Photobiomodulation, Neuromodulation, and Drug Therapy in Neuropsychiatry. A Promising Strategy to Enhance PBM Adoption and Neurotherapy EfficacyFarzan Vahedifard*. Synergistic Approach: Photobiomodulation, Neuromodulation, and Drug Therapy in Neuropsychiatry. A Promising Strategy to Enhance PBM Adoption and Neurotherapy Efficacy. J Neurosci Neurol Disord. 2023: doi: 10.29328/journal.jnnd.1001079; 7: 057-060
-
Update in the Understanding, Diagnosis, and Management of Sturge Weber Syndrome: Case ReportMariana Catalina Garcini Sandoval*, Enrique Espinosa Zúñiga, Martha Guadalupe García Toribio. Update in the Understanding, Diagnosis, and Management of Sturge Weber Syndrome: Case Report. J Neurosci Neurol Disord. 2023: doi: 10.29328/journal.jnnd.1001080; 7: 061-064
-
The Dynamics of Eating Behavior Disorders and the Level of General Psychological Adaptation in Bodybuilding and Fitness AthletesElena Mihaita*, Georgeta Mitrache, Marius Stoica, Rocsana Manea Bucea Tonis. The Dynamics of Eating Behavior Disorders and the Level of General Psychological Adaptation in Bodybuilding and Fitness Athletes. J Neurosci Neurol Disord. 2023: doi: 10.29328/journal.jnnd.1001081; 7: 065-089
-
Interconnection and Communication between Bone Marrow - The Central Immune System - And the Central Nervous SystemVolker Schirrmacher*. Interconnection and Communication between Bone Marrow - The Central Immune System - And the Central Nervous System. J Neurosci Neurol Disord. 2023: doi: 10.29328/journal.jnnd.1001082; 7: 090-093
Most Viewed
-
Feasibility study of magnetic sensing for detecting single-neuron action potentialsDenis Tonini,Kai Wu,Renata Saha,Jian-Ping Wang*. Feasibility study of magnetic sensing for detecting single-neuron action potentials. Ann Biomed Sci Eng. 2022 doi: 10.29328/journal.abse.1001018; 6: 019-029
-
Evaluation of In vitro and Ex vivo Models for Studying the Effectiveness of Vaginal Drug Systems in Controlling Microbe Infections: A Systematic ReviewMohammad Hossein Karami*, Majid Abdouss*, Mandana Karami. Evaluation of In vitro and Ex vivo Models for Studying the Effectiveness of Vaginal Drug Systems in Controlling Microbe Infections: A Systematic Review. Clin J Obstet Gynecol. 2023 doi: 10.29328/journal.cjog.1001151; 6: 201-215
-
Causal Link between Human Blood Metabolites and Asthma: An Investigation Using Mendelian RandomizationYong-Qing Zhu, Xiao-Yan Meng, Jing-Hua Yang*. Causal Link between Human Blood Metabolites and Asthma: An Investigation Using Mendelian Randomization. Arch Asthma Allergy Immunol. 2023 doi: 10.29328/journal.aaai.1001032; 7: 012-022
-
An algorithm to safely manage oral food challenge in an office-based setting for children with multiple food allergiesNathalie Cottel,Aïcha Dieme,Véronique Orcel,Yannick Chantran,Mélisande Bourgoin-Heck,Jocelyne Just. An algorithm to safely manage oral food challenge in an office-based setting for children with multiple food allergies. Arch Asthma Allergy Immunol. 2021 doi: 10.29328/journal.aaai.1001027; 5: 030-037
-
Postpartum as the best time for physical recovery and health careShizuka Torashima*,Mina Samukawa,Kazumi Tsujino,Yumi Sawada. Postpartum as the best time for physical recovery and health care. J Nov Physiother Rehabil. 2023 doi: 10.29328/journal.jnpr.1001049; 7: 001-007

If you are already a member of our network and need to keep track of any developments regarding a question you have already submitted, click "take me to my Query."























































































































































